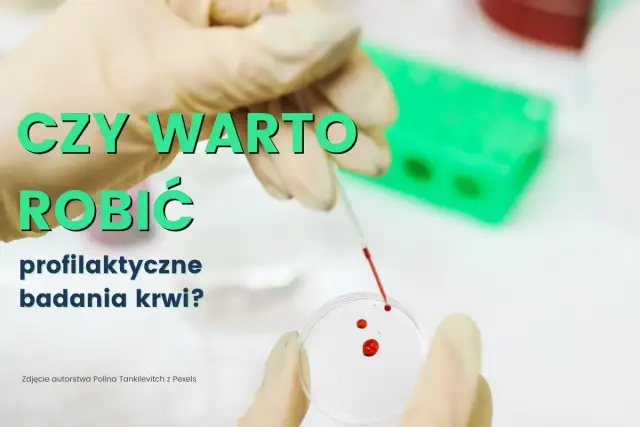
Badania krwi, które warto zrobić – kluczowe testy dla zdrowia i profilaktyki

Skuteczne suplementy na obniżenie kortyzolu i redukcję stresu
3 marca 2025
Poznaj skuteczne suplementy na obniżenie kortyzolu, które pomogą w redukcji stresu i poprawią Twoje samopoczucie. Sprawdź, jakie składniki są najskuteczniejsze!

3 marca 2025
Poznaj skuteczne suplementy na obniżenie kortyzolu, które pomogą w redukcji stresu i poprawią Twoje samopoczucie. Sprawdź, jakie składniki są najskuteczniejsze!

2 marca 2025
Poznaj skuteczne suplementy na depresję, które mogą poprawić Twój nastrój. Dowiedz się, jak witaminy i zioła wspierają zdrowie psychiczne.

1 marca 2025
Poznaj najlepsze suplementy dla piłkarza, które poprawiają wydolność i regenerację. Dowiedz się, jak wspierać swoje osiągi na boisku!

26 lutego 2025
Poznaj kluczowe różnice między lekami a suplementami diety. Dowiedz się, czym różni się lek od suplementu i jak wpływa to na Twoje zdrowie.

20 stycznia 2025
Ile kosztuje badanie TSH bez skierowania? Sprawdź ceny, dostępne miejsca oraz opcje w Warszawie. Dowiedz się, jakie są ceny badań TSH w 2023 roku.

19 stycznia 2025
Dowiedz się, jakie suplementy do testosteronu są najskuteczniejsze i jak uniknąć błędów w dawkowaniu. Poznaj naturalne sposoby na podwyższenie poziomu testosteronu.
19 stycznia 2025
Badania krwi, które warto zrobić, to kluczowe testy dla zdrowia. Sprawdź, jakie badania krwi profilaktyczne powinieneś wykonać, aby monitorować swoje samopoczucie.

19 stycznia 2025
Czy badanie poziomu witaminy B12 jest refundowane? Sprawdź, kiedy NFZ pokrywa koszty, ile zapłacisz bez refundacji i gdzie wykonać badanie. Dowiedz się więcej!

19 stycznia 2025
Biegunka przy okresie jak zapobiec? Sprawdź przyczyny, skuteczne diety oraz domowe sposoby na złagodzenie objawów podczas menstruacji.

18 stycznia 2025
Dowiedz się, co to jest suplementy diety, jakie są ich rodzaje, korzyści i zagrożenia. Sprawdź, jak wybrać odpowiednie suplementy i czy warto je stosować.

9 maja 2025

7 maja 2025

6 maja 2025

3 maja 2025

10 maja 2025

10 maja 2025

9 maja 2025

8 maja 2025